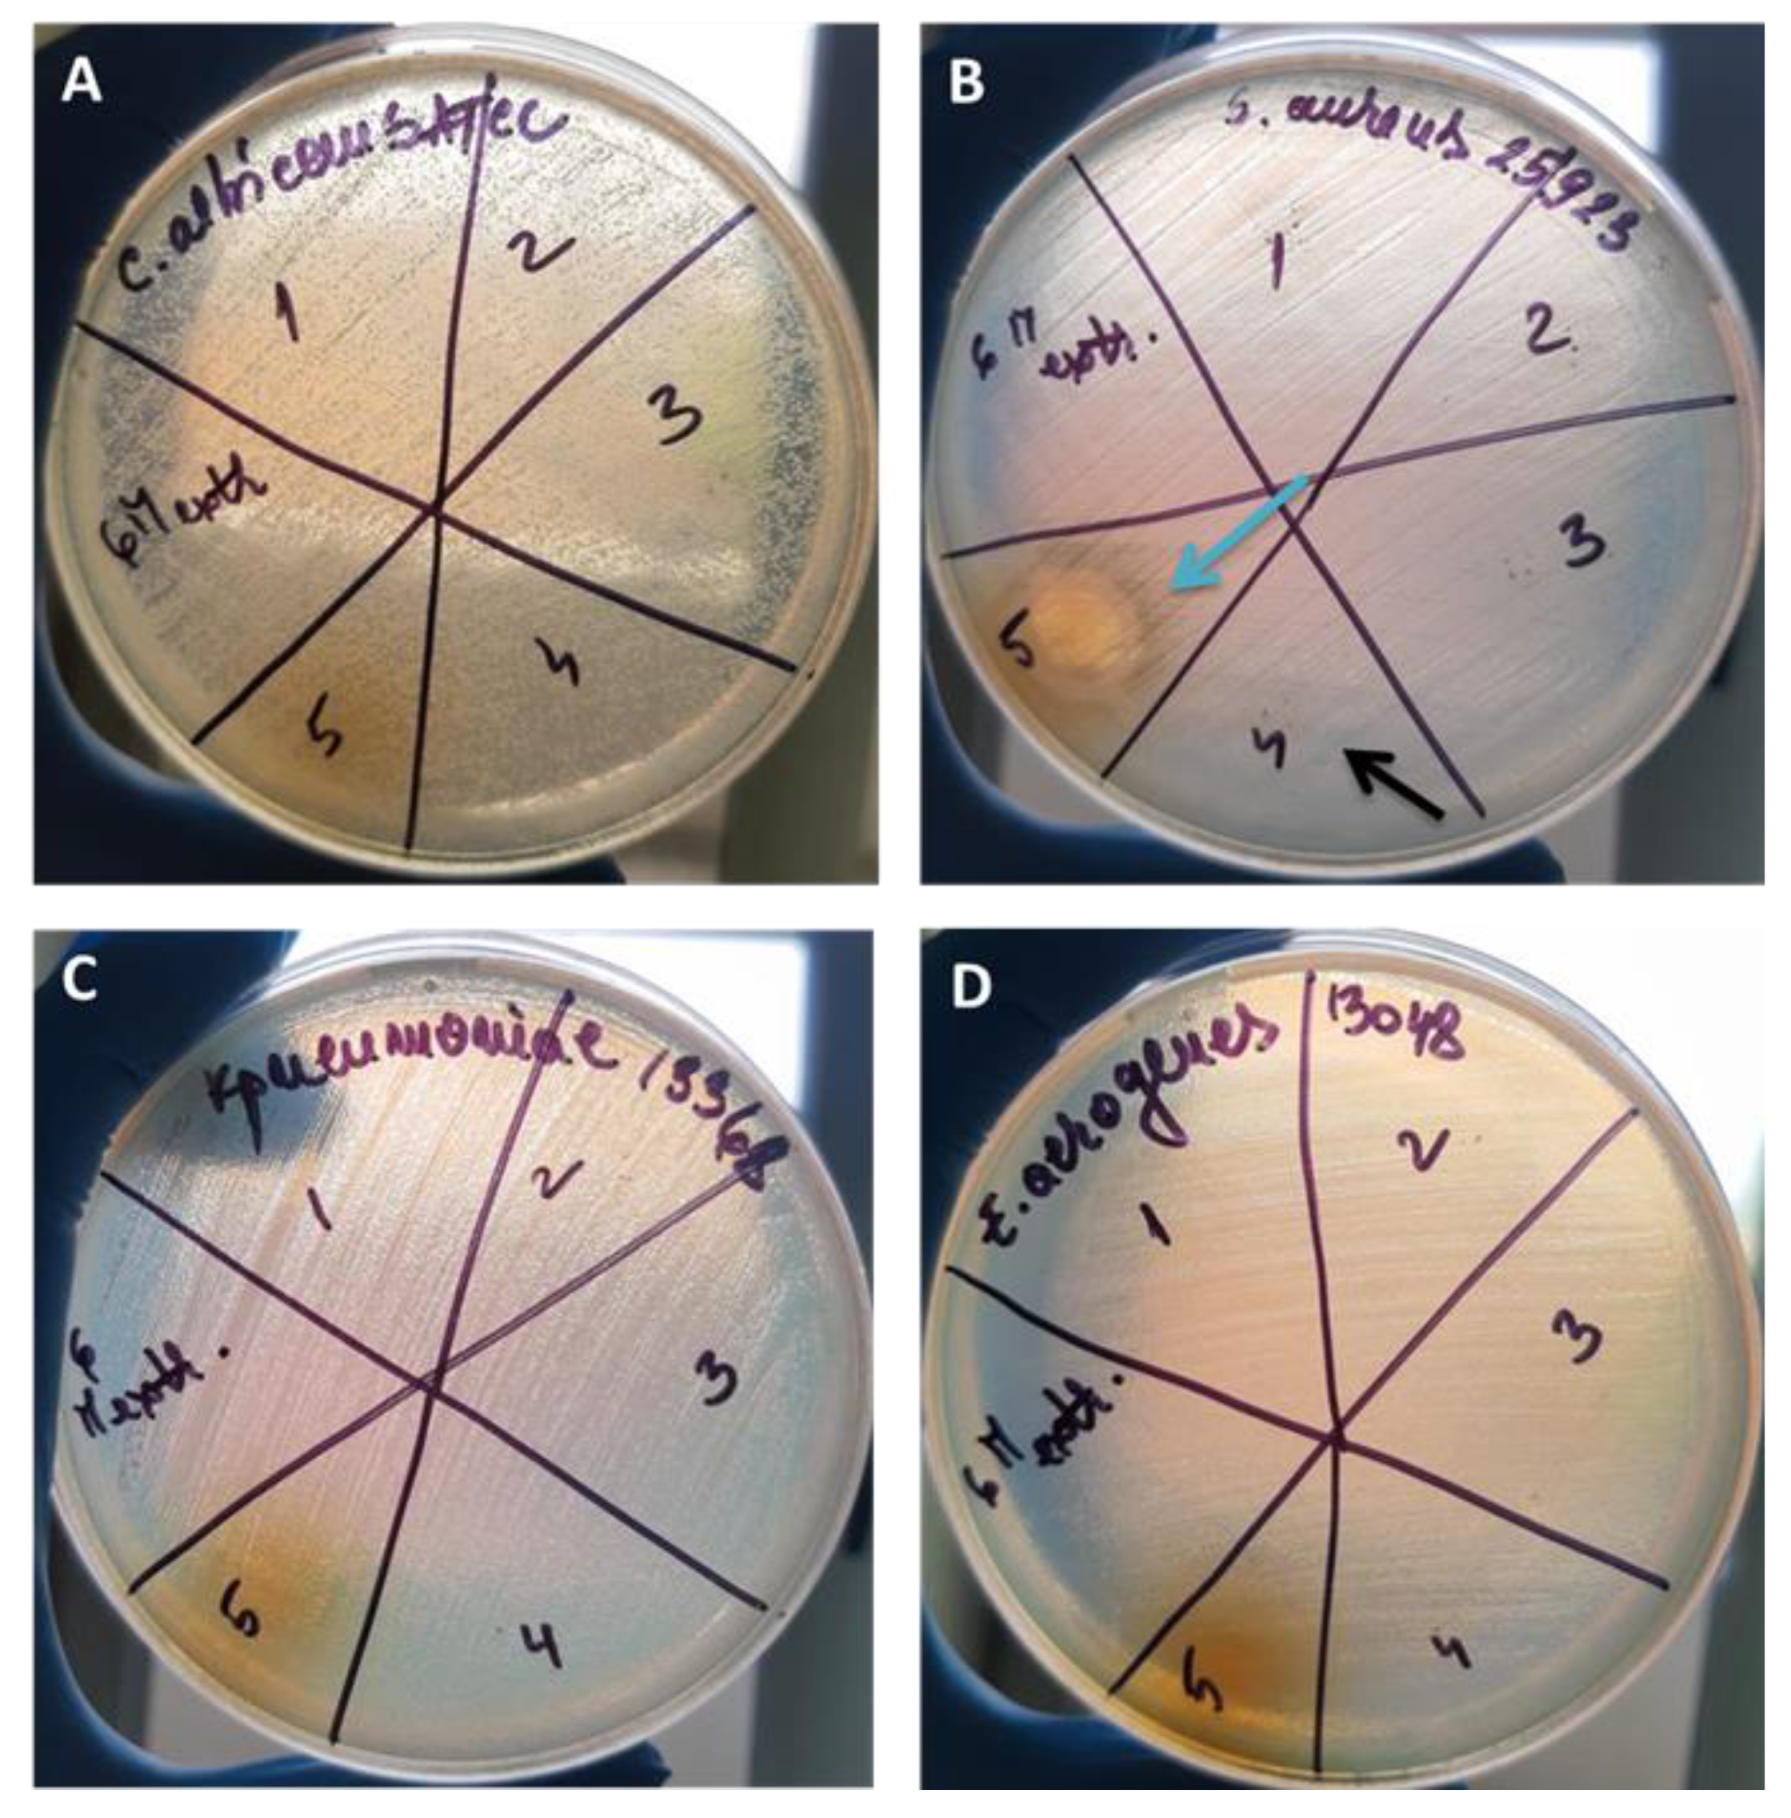
Pharmaceutics 16 00525 g008 Pharmaceutics 16 00525 g008

The Antimicrobial Potency of Mesoporous Silica Nanoparticles Loaded with Melissa officinalis Extract
Abstract
1. Introduction
2. Materials and Methods
2.1. Materials
2.2. Equipment
2.3. Obtaining and Characterizing the Melissa officinalis Extract
2.4. Preparation of Mesoporous Materials and Adsorption of MOE
2.5. Determination of Total Polyphenol Content (TPC)
2.6. Qualitative Testing of Antimicrobial Activity against Reference Microbial Strains
2.7. The Influence of MOE-Loaded MSNs on the Adherence Ability of Microbial Strains to an Inert Substrate
2.8. The Influence of MOE-Loaded MSNs on the Ability to Secrete Soluble Virulence Factors
2.9. Statistical Analysis
3. Results and Discussion
3.1. Characterization of M. officinalis Plant Extract
3.2. Characterization of MSNs Loaded with M. officinalis Extract
3.3. Characterization of MSNs Loaded with M. officinalis Extract
3.4. The Influence of the Mesoporous Materials on the Ability to Adhere to an Inert Substrate
3.5. Highlighting Antimicrobial Activity against Microbial Strains Isolated from Intra-Hospital Infections
3.6. The Influence of Nanoparticle Solutions on the Ability to Secrete Soluble Virulence Factors and the Ability to Adhere to the Inert Substrate
4. Conclusions
Supplementary Materials
Author Contributions
Funding
Institutional Review Board Statement
Informed Consent Statement
Data Availability Statement
Conflicts of Interest
Abbreviations
| MOE | Melissa officinalis extract |
| MCM-41 | Mobile Composition of Matter No 41 |
| MCM-48 | Mobile Composition of Matter No 48 |
| APTES | (3-aminopropyl) triethoxysilane |
| MCM-41@APTES | MCM-41 particles functionalized with APTES |
| MCM-48@APTES | MCM-48 particles functionalized with APTES |
| MCM-41@APTES@MOE | MCM-41@APTES particles loaded with MOE |
| MCM-48@APTES@MOE | MCM-48@APTES particles loaded with MOE |
| MSNs | mesoporous silica nanoparticles |
| TEOS | tetraethyl orthosilicate |
| CTAB | cetyltrimethylammonium bromide |
| TEM | transmission electron microscope |
| SEM | scanning electron microscopy |
| TG | thermogravimetric analysis |
| DSC | differential scanning calorimetry |
| FTIR | Fourier-transform infrared spectroscopy |
| BET | Brunauer–Emmett–Teller |
| HPLC | high-performance liquid chromatography |
| TPC | total polyphenol content |
| MIC | minimum inhibitory concentration |
| MRSA | methicillin-resistant S. aureus |
| MAI | microbial adherence inhibition |
References
- Negreanu-Pirjol, B.S.; Oprea, O.C.; Negreanu-Pirjol, T.; Roncea, F.N.; Prelipcean, A.M.; Craciunescu, O.; Iosageanu, A.; Artem, V.; Ranca, A.; Motelica, L.; et al. Health Benefits of Antioxidant Bioactive Compounds in the Fruits and Leaves of Lonicera caerulea L. and Aronia melanocarpa (Michx.) Elliot. Antioxidants 2023, 12, 951. [Google Scholar] [CrossRef]
- Lamaison, J.L.; Petitjeanfreytet, C.; Carnat, A. Medicinal Lamiaceae with Antioxidative Activity, Potential Sources of Rosmarinic Acid. Pharm. Acta Helv. 1991, 66, 185–188. [Google Scholar]
- Abdellatif, F.; Boudjella, H.; Zitouni, A.; Hassani, A. Chemical composition and antimicrobial activity of the essential oil from leaves of Algerian Melissa officinalis L. EXCLI J. 2014, 13, 772–781. [Google Scholar]
- Zazharskyi, V.V.; Davydenko, P.O.; Kulishenko, M.; Borovik, I.V.; Brygadyrenko, V.V. Antimicrobial activity of 50 plant extracts. Biosyst. Divers. 2019, 27, 163–169. [Google Scholar] [CrossRef]
- Huang, X.Y.; Young, N.P.; Townley, H.E. Characterization and Comparison of Mesoporous Silica Particles for Optimized Drug Delivery. Nanomater. Nanotechno. 2014, 4, 2. [Google Scholar] [CrossRef]
- Ghiulai, R.; Avram, S.; Stoian, D.; Pavel, I.Z.; Coricovac, D.; Oprean, C.; Vlase, L.; Farcas, C.; Mioc, M.; Minda, D.; et al. Lemon Balm Extracts Prevent Breast Cancer Progression In Vitro and In Ovo on Chorioallantoic Membrane Assay. Evid.-Based Compl. Alt. 2020, 2020, 6489159. [Google Scholar] [CrossRef]
- Kamdem, J.P.; Adeniran, A.; Boligon, A.A.; Klimaczewski, C.V.; Elekofehinti, O.O.; Hassan, W.; Ibrahim, M.; Waczuk, E.P.; Meinerz, D.F.; Athayde, M.L. Antioxidant activity, genotoxicity and cytotoxicity evaluation of lemon balm (Melissa officinalis L.) ethanolic extract: Its potential role in neuroprotection. Ind. Crop Prod. 2013, 51, 26–34. [Google Scholar] [CrossRef]
- Saraydin, S.U.; Tuncer, E.; Tepe, B.; Karadayi, S.; Ozer, H.; Sen, M.; Karadayi, K.; Inan, D.; Elagoz, S.; Polat, Z.; et al. Antitumoral effects of Melissa officinalis on breast cancer in vitro and in vivo. Asian Pac. J. Cancer Prev. 2012, 13, 2765–2770. [Google Scholar] [CrossRef]
- Borgonetti, V.; Governa, P.; Biagi, M.; Galeotti, N. Novel Therapeutic Approach for the Management of Mood Disorders: In Vivo and In Vitro Effect of a Combination of L-Theanine, Melissa officinalis L. and Magnolia officinalis Rehder & E.H. Wilson. Nutrients 2020, 12, 1803. [Google Scholar] [CrossRef]
- Ghazizadeh, J.; Hamedeyazdan, S.; Torbati, M.; Farajdokht, F.; Fakhari, A.; Mahmoudi, J.; Araj-khodaei, M.; Sadigh-Eteghad, S. Melissa officinalis L. hydro-alcoholic extract inhibits anxiety and depression through prevention of central oxidative stress and apoptosis. Exp. Physiol. 2020, 105, 707–720. [Google Scholar] [CrossRef]
- Bayat, M.; Tameh, A.A.; Ghahremani, M.H.; Akbari, M.; Mehr, S.E.; Khanavi, M.; Hassanzadeh, G. Neuroprotective properties of Melissa officinalis after hypoxic-ischemic injury both in vitro and in vivo. Daru J. Pharm. Sci. 2012, 20, 42. [Google Scholar] [CrossRef] [PubMed]
- Asadi, A.; Shidfar, F.; Safari, M.; Hosseini, A.F.; Huseini, H.F.; Heidari, I.; Rajab, A. Efficacy of Melissa officinalis L. (lemon balm) extract on glycemic control and cardiovascular risk factors in individuals with type 2 diabetes: A randomized, double-blind, clinical trial. Phytother. Res. 2019, 33, 651–659. [Google Scholar] [CrossRef] [PubMed]
- Bounihi, A.; Hajjaj, G.; Alnamer, R.; Cherrah, Y.; Zellou, A. In Vivo Potential Anti-Inflammatory Activity of Melissa officinalis L. Essent. Oil. Adv. Pharmacol. Sci. 2013, 2013, 101759. [Google Scholar]
- Spiridon, I.; Bodirlau, R.; Teaca, C.A. Total phenolic content and antioxidant activity of plants used in traditional Romanian herbal medicine. Cent. Eur. J. Biol. 2011, 6, 388–396. [Google Scholar] [CrossRef]
- Petrisor, G.; Motelica, L.; Craciun, L.N.; Oprea, O.C.; Ficai, D.; Ficai, A. Melissa officinalis: Composition, Pharmacological Effects and Derived Release Systems—A Review. Int. J. Mol. Sci. 2022, 23, 3591. [Google Scholar] [CrossRef] [PubMed]
- Fenton, O.S.; Olafson, K.N.; Pillai, P.S.; Mitchell, M.J.; Langer, R. Advances in Biomaterials for Drug Delivery. Adv. Mater. 2018, 30, e1705328. [Google Scholar] [CrossRef] [PubMed]
- Kiparissides, C.; Kammona, O. Nanotechnology advances in controlled drug delivery systems. Phys. Status Solidi C 2008, 5, 3828–3833. [Google Scholar] [CrossRef]
- Lombardo, D.; Kiselev, M.A.; Caccamo, M.T. Smart Nanoparticles for Drug Delivery Application: Development of Versatile Nanocarrier Platforms in Biotechnology and Nanomedicine. J. Nanomater. 2019, 2019, e3702518. [Google Scholar] [CrossRef]
- Motelica, L.; Vasile, B.-S.; Ficai, A.; Surdu, A.-V.; Ficai, D.; Oprea, O.-C.; Andronescu, E.; Mustățea, G.; Ungureanu, E.L.; Dobre, A.A. Antibacterial activity of zinc oxide nanoparticles loaded with essential oils. Pharmaceutics 2023, 15, 2470. [Google Scholar] [CrossRef]
- Wu, S.H.; Hung, Y.; Mou, C.Y. Mesoporous silica nanoparticles as nanocarriers. Chem. Commun. 2011, 47, 9972–9985. [Google Scholar] [CrossRef]
- Rastegari, E.; Hsiao, Y.-J.; Lai, W.-Y.; Lai, Y.-H.; Yang, T.-C.; Chen, S.-J.; Huang, P.-I.; Chiou, S.-H.; Mou, C.-Y.; Chien, Y. An Update on Mesoporous Silica Nanoparticle Applications in Nanomedicine. Pharmaceutics 2021, 13, 1067. [Google Scholar] [CrossRef] [PubMed]
- Murugan, B.; Sagadevan, S.; Lett J, A.; Fatimah, I.; Fatema, K.N.; Oh, W.-C.; Mohammad, F.; Johan, M.R. Role of mesoporous silica nanoparticles for the drug delivery applications. Mater. Res. Express. 2020, 7, 102002. [Google Scholar] [CrossRef]
- Nayl, A.A.; Abd-Elhamid, A.I.; Aly, A.A.; Brase, S. Recent progress in the applications of silica-based nanoparticles. Rsc Adv. 2022, 12, 13706–13726. [Google Scholar] [CrossRef] [PubMed]
- Žid, L.; Zeleňák, V.; Almáši, M.; Zeleňáková, A.; Szücsová, J.; Bednarčík, J.; Šuleková, M.; Hudák, A.; Váhovská, L. Mesoporous Silica as a Drug Delivery System for Naproxen: Influence of Surface Functionalization. Molecules 2020, 25, 4722. [Google Scholar] [CrossRef] [PubMed]
- Bharti, C.; Nagaich, U.; Pal, A.K.; Gulati, N. Mesoporous silica nanoparticles in target drug delivery system: A review. Int. J. Pharm. Investig. 2015, 5, 124–133. [Google Scholar] [CrossRef] [PubMed]
- Vinu, A.; Hossain, K.Z.; Ariga, K. Recent advances in functionalization of mesoporous silica. J. Nanosci. Nanotechno. 2005, 5, 347–371. [Google Scholar] [CrossRef]
- Yasmin, T.; Muller, K. Synthesis and surface modification of mesoporous mcm-41 silica materials. J. Chromatogr. A 2010, 1217, 3362–3374. [Google Scholar] [CrossRef] [PubMed]
- Szegedi, A.; Popova, M.; Goshev, I.; Klebert, S.; Mihaly, J. Controlled drug release on amine functionalized spherical MCM-41. J. Solid State Chem. 2012, 194, 257–263. [Google Scholar] [CrossRef]
- Najafi, A.; Khosravian, P.; Validi, M.; Daryasari, M.P.; Drees, F.; Gholipour, A. Antimicrobial action of mesoporous silica nanoparticles loaded with cefepime and meropenem separately against multidrug-resistant (MDR). J. Drug Deliv. Sci. Tec. 2021, 65, 102757. [Google Scholar] [CrossRef]
- Subramaniam, S.; Thomas, N.; Gustafsson, H.; Jambhrunkar, M.; Kidd, S.P.; Prestidge, C.A. Rifampicin-Loaded Mesoporous Silica Nanoparticles for the Treatment of Intracellular Infections. Antibiotics 2019, 8, 39. [Google Scholar] [CrossRef]
- Abbasi, M.; Gholizadeh, R.; Kasaee, S.R.; Vaez, A.; Chelliapan, S.; Fadhil Al-Qaim, F.; Deyab, I.F.; Shafiee, M.; Zareshahrabadi, Z.; Amani, A.M.; et al. An intriguing approach toward antibacterial activity of green synthesized Rutin-templated mesoporous silica nanoparticles decorated with nanosilver. Sci. Rep. 2023, 13, 5987. [Google Scholar] [CrossRef] [PubMed]
- Petrișor, G.; Motelica, L.; Ficai, D.; Ilie, C.I.; Trușcǎ, R.D.; Surdu, V.A.; Oprea, O.C.; Mȋrț, A.L.; Vasilievici, G.; Semenescu, A.; et al. Increasing Bioavailability of Trans-Ferulic Acid by Encapsulation in Functionalized Mesoporous Silica. Pharmaceutics 2023, 15, 660. [Google Scholar] [CrossRef] [PubMed]
- Petrisor, G.; Ficai, D.; Motelica, L.; Trusca, R.D.; Bîrcă, A.C.; Vasile, B.S.; Voicu, G.; Oprea, O.C.; Semenescu, A.; Ficai, A.; et al. Mesoporous Silica Materials Loaded with Gallic Acid with Antimicrobial Potential. Nanomaterials 2022, 12, 1648. [Google Scholar] [CrossRef] [PubMed]
- Petrisor, G.; Motelica, L.; Ficai, D.; Trusca, R.D.; Surdu, V.-A.; Voicu, G.; Oprea, O.C.; Ficai, A.; Andronescu, E. New Mesoporous Silica Materials Loaded with Polyphenols: Caffeic Acid, Ferulic Acid and p-Coumaric Acid as Dietary Supplements for Oral Administration. Materials 2022, 15, 7982. [Google Scholar] [CrossRef]
- Šne, E.; Segliņa, D.; Galoburda, R.; Krasnova, I. Content of Phenolic Compounds in Various Sea Buckthorn Parts. Proc. Latv. Acad. Sci. 2013, 67, 411–415. [Google Scholar] [CrossRef]
- Espinel-Ingroff, A.; Cantón, E.; Pemán, J. Antifungal susceptibility testing of filamentous fungi. Curr. Fungal Infect. Rep. 2012, 6, 41–50. [Google Scholar] [CrossRef]
- Aboukhalaf, A.; El Amraoui, B.; Tabatou, M.; da Rocha, J.M.F.; Belahsen, R. Screening of the antimicrobial activity of some extracts of edible wild plants in Morocco. Funct. Foods Health Dis. 2020, 10, 265–273. [Google Scholar] [CrossRef]
- Sytar, O.; Svediene, J.; Loziene, K.; Paskevicius, A.; Kosyan, A.; Taran, N. Antifungal properties of hypericin, hypericin tetrasulphonic acid and fagopyrin on pathogenic fungi and spoilage yeasts. Pharm. Biol. 2016, 54, 3121–3125. [Google Scholar] [CrossRef] [PubMed]
- Corbu, V.M.; Gheorghe, I.; Marinaș, I.C.; Geană, E.I.; Moza, M.I.; Csutak, O.; Chifiriuc, M.C. Demonstration of Allium sativum Extract Inhibitory Effect on Biodeteriogenic Microbial Strain Growth, Biofilm Development, and Enzymatic and Organic Acid Production. Molecules 2021, 26, 7195. [Google Scholar] [CrossRef]
- Truşcă, B.S.; Gheorghe-Barbu, I.; Manea, M.; Ianculescu, E.; Barbu, I.C.; Măruțescu, L.G.; Dițu, L.-M.; Chifiriuc, M.-C.; Lazăr, V. Snapshot of Phenotypic and Molecular Virulence and Resistance Profiles in Multidrug-Resistant Strains Isolated in a Tertiary Hospital in Romania. Pathogens 2023, 12, 609. [Google Scholar] [CrossRef] [PubMed]
- Gayibova, S.; Ivanišová, E.; Árvay, J.; Hŕstková, M.; Slávik, M.; Petrová, J.; Hleba, L.; Tóth, T.; Kačániová, M.; Aripov, T. In Vitro Screening of Antioxidant and Antimicrobial Activities of Medicinal Plants Growing in Slovakia. J. Microb. Biotec Food. 2019, 8, 1281–1289. [Google Scholar] [CrossRef]
- Zhao, J.; Xu, L.; Jin, D.; Xin, Y.; Tian, L.; Wang, T.; Zhao, D.; Wang, Z.; Wang, J. Rosmarinic Acid and Related Dietary Supplements: Potential Applications in the Prevention and Treatment of Cancer. Biomolecules 2022, 12, 1410. [Google Scholar] [CrossRef] [PubMed]
- Kernou, O.-N.; Azzouz, Z.; Madani, K.; Rijo, P. Application of Rosmarinic Acid with Its Derivatives in the Treatment of Microbial Pathogens. Molecules 2023, 28, 4243. [Google Scholar] [CrossRef] [PubMed]
- Enache, D.F.; Vasile, E.; Simonescu, C.M.; Răzvan, A.; Nicolescu, A.; Nechifor, A.-C.; Oprea, O.; Pătescu, R.-E.; Onose, C.; Dumitru, F. Cysteine-functionalized silica-coated magnetite nanoparticles as potential nanoadsorbents. J. Solid. State Chem. 2017, 253, 318–328. [Google Scholar] [CrossRef]
- Stoyanova, N.; Spasova, M.; Manolova, N.; Rashkov, I.; Kamenova-Nacheva, M.; Staleva, P.; Tavlinova-Kirilova, M. Electrospun PLA-Based Biomaterials Loaded with Melissa officinalis Extract with Strong Antioxidant Activity. Polymers 2023, 15, 1070. [Google Scholar] [CrossRef] [PubMed]
- Benhamou, A.; Baudu, M.; Derriche, Z.; Basly, J.P. Aqueous heavy metals removal on amine-functionalized Si-MCM-41 and Si-MCM-48. J. Hazard Mater. 2009, 171, 1001–1008. [Google Scholar] [CrossRef]
- Mohamad, F.; Alzahrani, R.R.; Alsaadi, A.; Alrfaei, B.M.; Yassin, A.E.B.; Alkhulaifi, M.M.; Halwani, M. An Explorative Review on Advanced Approaches to Overcome Bacterial Resistance by Curbing Bacterial Biofilm Formation. Infect. Drug Resist. 2023, 16, 19–49. [Google Scholar] [CrossRef] [PubMed]
- Andrade, S.; Ramalho, M.J.; Santos, S.B.; Melo, L.D.R.; Santos, R.S.; Guimarães, N.; Azevedo, N.F.; Loureiro, J.A.; Pereira, M.C. Fighting Methicillin-Resistant Staphylococcus aureus with Targeted Nanoparticles. Int. J. Mol. Sci. 2023, 24, 9030. [Google Scholar] [CrossRef] [PubMed]
- Singh, S.; Numan, A.; Somaily, H.H.; Gorain, B.; Ranjan, S.; Rilla, K.; Siddique, H.R.; Kesharwani, P. Nano-enabled strategies to combat methicillin-resistant Staphylococcus aureus. Mater. Sci. Eng. C Mater. Biol. Appl. 2021, 129, 112384. [Google Scholar] [CrossRef] [PubMed]
- Castillo, R.R.; Vallet-Regi, M. Recent Advances Toward the Use of Mesoporous Silica Nanoparticles for the Treatment of Bacterial Infections. Int. J. Nanomed. 2021, 16, 4409–4430. [Google Scholar] [CrossRef] [PubMed]
- Balaure, P.C.; Boarca, B.; Popescu, R.C.; Savu, D.; Trusca, R.; Vasile, B.Ș.; Grumezescu, A.M.; Holban, A.M.; Bolocan, A.; Andronescu, E. Bioactive mesoporous silica nanostructures with anti-microbial and anti-biofilm properties. Int. J. Pharm. 2017, 531, 35–46. [Google Scholar] [CrossRef] [PubMed]
- Hăncianu, M.; Aprotosoaie, A.C.; Gille, E.; Poiată, A.; Tuchiluş, C.; Spac, A.; Stănescu, U. Chemical composition and in vitro antimicrobial activity of essential oil of Melissa officinalis L. from Romania. Rev. Med. Chir. Soc. Med. Nat. Iasi. 2008, 112, 843–847. [Google Scholar] [PubMed]
- Abdellatif, F.; Akram, M.; Begaa, S.; Messaoudi, M.; Benarfa, A.; Egbuna, C.; Ouakouak, H.; Hassani, A.; Sawicka, B.; Elbossaty, W.F.M.; et al. Minerals, Essential Oils, and Biological Properties of Melissa officinalis L. Plants 2021, 10, 1066. [Google Scholar] [CrossRef] [PubMed]

| Material Type | Sample Code |
|---|---|
| MCM-41@Melissa officinalis extract | MCM-41@MOE |
| MCM-41@(3-aminopropyl)triethoxysilane@Melissa officinalis extract | MCM-41@APTES@MOE |
| MCM-48@Melissa officinalis extract | MCM-48@MOE |
| MCM-48@(3-aminopropyl)triethoxysilane@Melissa officinalis extract | MCM-48@APTES@MOE |
| Standard Substance | Estimated Quantity of Loaded Polyphenol (mg/5 mL Extract) |
|---|---|
| Chlorogenic acid | 1.8 |
| Caffeic acid | 1.15 |
| Cichoric acid | 1.5 |
| Rosmarinic acid | 64.3 |
| Sample | TPC (g Caffeic Acid Equivalent/100 g Extract) | TPC (g Chlorogenic Acid Equivalent/100 g Extract) |
|---|---|---|
| MOE | 3.14 | 6.33 |
| Sample | Volume of Pores cm3/g | BET Surface Area m2/g |
|---|---|---|
| MCM-41 | 0.783 | 1365 |
| MCM-41@MOE | 0.1024 | 143.9 |
| MCM-41@APTES | 0.5706 | 1014 |
| MCM-41@APTES@MOE | 0.0295 | 22.43 |
| MCM-48 | 0.9423 | 1582 |
| MCM-48@MOE | 0.1074 | 143.8 |
| MCM-48@APTES | 0.7371 | 1555 |
| MCM-48@APTES@MOE | 0.0835 | 76.14 |
| Mass Loss (%) RT-125 °C | Endo (°C) | Mass Loss (%) 125–300 °C | Exo (°C) | Mass Loss (%) 300–520 °C | Exo (°C) | Estimated MOE Load (%) | |
|---|---|---|---|---|---|---|---|
| MCM-41@MOE | 11.89 | 84.1 | 18.52 | 271.2 | 16.00 | 318.0/417.3 | 46.45 |
| MCM-41@APTES @MOE | 4.65 | 90.3 | 20.96 | 272.1 | 18.55 | 321.7/421.6 | 35.86 |
| MCM-48@MOE | 21.70 | 88.4 | 15.39 | 277.4 | 12.82 | 325.9/426.6 | 50.02 |
| MCM-48@APTES @MOE | 10.41 | 84.9 | 15.20 | 276.8 | 16.57 | 323.1/432.3 | 32.24 |
| Antimicrobial Compound | S.aureus ATCC 25923 | E. coli ATCC 13846 | E. coli ATCC 25922 | E. coli ATCC 8732 | C. albicans ATCC 10231 | E. faecium ATCC 29212 | E. aerogenes ATCC 13048 | P. aeruginosa ATCC 28792 | K. pneumoniae ATCC 13368 | |
|---|---|---|---|---|---|---|---|---|---|---|
| MCM-41@ MOE | MIC (mg/mL) | 1.25 ± 0.0 | 10 ± 0.0 | 10 ± 0.0 | 0.312 ± 0.0 | 2.5 ± 0.0 | 2.5 ± 0.0 | 1.25 ± 0.0 | 10 ± 0.0 | 10 ± 0.0 |
| MIC/2 (mg/mL) | 0.625 | 5 | 5 | 0.156 | 1.25 | 1.25 | 0.625 | 5 | 5 | |
| MIC/4 (mg/mL) | 0.3125 | 2.5 | 2.5 | 0.078 | 0.625 | 0.625 | 0.3125 | 2.5 | 2.5 | |
| MCM-41 @APTES @MOE | MIC (mg/mL) | 0.156 ± 0.0 | 10 ± 0.0 | 10 ± 0.0 | 10 ± 0.0 | 2.5 ± 0.0 | 2.5 ± 0.0 | 5 ± 0.0 | 10 ± 0.0 | 10 ± 0.0 |
| MIC/2 (mg/mL) | 0.078 | 5 | 5 | 5 | 1.25 | 1.25 | 2.5 | 5 | 5 | |
| MIC/4 (mg/mL) | 0.03125 | 2.5 | 2.5 | 2.5 | 0.625 | 0.625 | 1.25 | 2.5 | 2.5 | |
| MCM-48 @MOE | MIC (mg/mL) | 0.625 ± 0.0 | 10 ± 0.0 | 10 ± 0.0 | 10 ± 0.0 | 2.5 ± 0.0 | 0.625 ± 0.0 | 10 ± 0.0 | 10 ± 0.0 | 10 ± 0.0 |
| MIC/2 (mg/mL) | 0.3125 | 5 | 5 | 5 | 1.25 | 0.3125 | 5 | 5 | 5 | |
| MIC/4 (mg/mL) | 0.156 | 2.5 | 2.5 | 2.5 | 0.625 | 0.156 | 2.5 | 2.5 | 2.5 | |
| MCM-48 @APTES @MOE | MIC (mg/mL) | 0.937 ± 0.54 | 10 ± 0.0 | 10 ± 0.0 | 10 ± 0.0 | 0.078 ± 0.0 | 2.5 ± 0.0 | 10 ± 0.0 | 1.04 ± 0.36 | 10 ± 0.0 |
| MIC/2 (mg/mL) | 0.468 | 5 | 5 | 5 | 0.039 | 1.25 | 5 | 0.52 | 5 | |
| MIC/4 (mg/mL) | 0.234 | 2.5 | 2.5 | 2.5 | 0.0195 | 0.625 | 2.5 | 0.26 | 2.5 | |
| Strains | MIC | MIC/2 | MIC/4 |
|---|---|---|---|
| S. aureus ATCC 25923 | 16.66 ± 10.20 | 8.33 | 4.16 |
| E. coli ATCC 13846 | 100 ± 0.0 | 50 | 25 |
| E. coli ATCC 25922 | 100 ± 0.0 | 50 | 25 |
| E. coli ATCC 8732 | 100 ± 0.0 | 50 | 25 |
| C. albicans ATCC 10231 | 100 ± 0.0 | 50 | 25 |
| E. faecium ATCC 29212 | 25 ± 0.0 | 12.5 | 6.25 |
| E. aerogenes ATCC 13048 | 12.5 ± 0.0 | 6.25 | 3.12 |
| P. aeruginosa ATCC 28792 | 41.66 ± 14.37 | 20.83 | 10.41 |
| K. pneumoniae ATCC 13368 | 100 ± 0.0 | 50 | 25 |
| Strains | MIC | MIC/2 |
|---|---|---|
| S. aureus SA3 | 12.5 ± 0.0 | 6.25 |
| S. aureus SA863 | 12.5 ± 0.0 | 6.25 |
| S. aureus SA74 | 12.5 ± 0.0 | 6.25 |
| S. aureus SA71 | 12.5 ± 0.0 | 6.25 |
| S. aureus SA30 | 12.5 ± 0.0 | 6.25 |
| S. aureus SA69 | 25 ± 0.0 | 12.5 |
| S. aureus SA125 | 25 ± 0.0 | 12.5 |
Disclaimer/Publisher’s Note: The statements, opinions and data contained in all publications are solely those of the individual author(s) and contributor(s) and not of MDPI and/or the editor(s). MDPI and/or the editor(s) disclaim responsibility for any injury to people or property resulting from any ideas, methods, instructions or products referred to in the content. |
© 2024 by the authors. Licensee MDPI, Basel, Switzerland. This article is an open access article distributed under the terms and conditions of the Creative Commons Attribution (CC BY) license (https://creativecommons.org/licenses/by/4.0/).
Share and Cite
Petrișor, G.; Motelica, L.; Trușcǎ, R.D.; Mȋrț, A.-L.; Vasilievici, G.; Tomescu, J.-A.; Manea, C.; Dumbravǎ, A.Ș.; Corbu, V.M.; Gheorghe-Barbu, I.; et al. The Antimicrobial Potency of Mesoporous Silica Nanoparticles Loaded with Melissa officinalis Extract. Pharmaceutics 2024, 16, 525. https://doi.org/10.3390/pharmaceutics16040525
Petrișor G, Motelica L, Trușcǎ RD, Mȋrț A-L, Vasilievici G, Tomescu J-A, Manea C, Dumbravǎ AȘ, Corbu VM, Gheorghe-Barbu I, et al. The Antimicrobial Potency of Mesoporous Silica Nanoparticles Loaded with Melissa officinalis Extract. Pharmaceutics. 2024; 16(4):525. https://doi.org/10.3390/pharmaceutics16040525
Chicago/Turabian StylePetrișor, Gabriela, Ludmila Motelica, Roxana Doina Trușcǎ, Andreea-Luiza Mȋrț, Gabriel Vasilievici, Justinian-Andrei Tomescu, Cristina Manea, Andreea Ștefania Dumbravǎ, Viorica Maria Corbu, Irina Gheorghe-Barbu, and et al. 2024. "The Antimicrobial Potency of Mesoporous Silica Nanoparticles Loaded with Melissa officinalis Extract" Pharmaceutics 16, no. 4: 525. https://doi.org/10.3390/pharmaceutics16040525
APA StylePetrișor, G., Motelica, L., Trușcǎ, R. D., Mȋrț, A.-L., Vasilievici, G., Tomescu, J.-A., Manea, C., Dumbravǎ, A. Ș., Corbu, V. M., Gheorghe-Barbu, I., Ficai, D., Oprea, O.-C., Vasile, B.-Ș., Ficai, A., & Raiciu, A. D. (2024). The Antimicrobial Potency of Mesoporous Silica Nanoparticles Loaded with Melissa officinalis Extract. Pharmaceutics, 16(4), 525. https://doi.org/10.3390/pharmaceutics16040525

